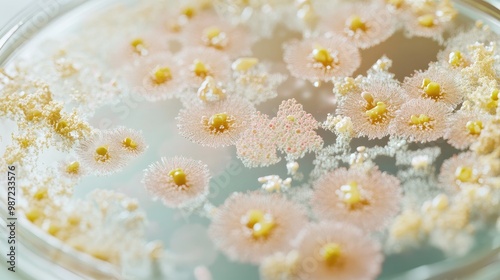
Bacteria and fungi growing in a petri dish, with a focus on the intricate details of microbial colonies on a plain surface.

More from this collection

Greeting Card Design With Tropical Flowers And Leaves.

Greeting Card Design With Tropical Flowers And Leaves.

Seamless Background With Floral Ornament. Illustration In Watercolor Style. Design For Packaging Design, Wrapping. Printing On Fabric And Paper.

Seamless Pattern With Bright Flowers. Background For Packaging Design, Wrapper, Invitation. Floral Ornament For Printing On Fabric And Paper.

Bright Floral Ornamental Background. Suitable For Printing On Scrapbooking Paper, Packaging, Wrapping, Postcard.
View All from Collection
Explore more designs
Similar Wallpaper designs

Close-up Of A Group Of Small White Flowers Scattered On A Bed Of Crushed Ice. The Flowers Have Five Petals Each And Are Arranged In A Scattered Manner, With Some Overlapping Each Other.

Yellow And Orange Dappled Sunlight On A White Background With Bright Pointillist Brushstrokes, Gentle Illumination, Colorful Brushstrokes, Dappled Light
Bacteria And Fungi Growing In A Petri Dish, With A Focus On The Intricate Details Of Microbial Colonies On A Plain Surface.

